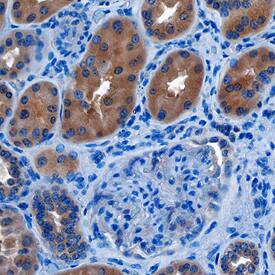
Transcobalamin II antibody in Human Kidney by Immunohistochemistry (IHC-P).

Human Transcobalamin II Antibody
R&D Systems, part of Bio-Techne | Catalog # AF7895


Key Product Details
Species Reactivity
Applications
Label
Antibody Source
Product Specifications
Immunogen
Glu19-Trp427
Accession # P20062
Specificity
Clonality
Host
Isotype
Scientific Data Images for Human Transcobalamin II Antibody
Detection of Human Transcobalamin II by Western Blot.
Western blot shows lysates of HUVEC human umbilical vein endothelial cells and RPMI 8226 human multiple myeloma cell line. PVDF membrane was probed with 1 µg/mL of Sheep Anti-Human/Mouse/Rat Transcobalamin II Antigen Affinity-purified Polyclonal Antibody (Catalog # AF7895) followed by HRP-conjugated Anti-Sheep IgG Secondary Antibody (Catalog # HAF016). A specific band was detected for Transcobalamin II at approximately 43 kDa (as indicated). This experiment was conducted under reducing conditions and using Immunoblot Buffer Group 1.Transcobalamin II in Human Kidney.
Transcobalamin II was detected in immersion fixed paraffin-embedded sections of human kidney using Sheep Anti-Human/Mouse/Rat Transcobalamin II Antigen Affinity-purified Polyclonal Antibody (Catalog # AF7895) at 10 µg/mL overnight at 4 °C. Before incubation with the primary antibody, tissue was subjected to heat-induced epitope retrieval using Antigen Retrieval Reagent-Basic (Catalog # CTS013). Tissue was stained using the Anti-Sheep HRP-DAB Cell & Tissue Staining Kit (brown; Catalog # CTS019) and counterstained with hematoxylin (blue). Specific staining was localized to the cytoplasm in epithelial cell convoluted tubules. View our protocol for Chromogenic IHC Staining of Paraffin-embedded Tissue Sections.Applications for Human Transcobalamin II Antibody
Immunohistochemistry
Sample: Immersion fixed paraffin-embedded sections of human kidney subjected to heat-induced epitope retrieval using Antigen Retrieval Reagent-Basic (Catalog # CTS013)
Western Blot
Sample: HUVEC human umbilical vein endothelial cells and RPMI 8226 human multiple myeloma cell line
Formulation, Preparation, and Storage
Purification
Reconstitution
Formulation
Shipping
Stability & Storage
- 12 months from date of receipt, -20 to -70 °C as supplied.
- 1 month, 2 to 8 °C under sterile conditions after reconstitution.
- 6 months, -20 to -70 °C under sterile conditions after reconstitution.
Background: Transcobalamin II
TCN2 (Transcobalamin II; also TC-2 or TC) is a 42-44 kDa, monomeric, secreted member of the eukaryotic cobalamin transport family of molecules. It is a key player in the transport and absorption of VitB12. TCN1 is a salivary gland protein that binds oral/dietary B12. Once in the stomach, B12 is transferred to IF/Intrinsic Factor, and this complex remains intact during passage through the small intestine. In the distal ileum, the IF:VitB12 complex is internalized following binding to cubam on enterocyte membranes. Once internalized, VitB12 is processed and re-expressed on MRP1 on the enterocyte's basal surface. Here it is transferred to TCN-2, a binding protein secreted by endothelial cells that accounts for the transport of anywhere from 10-30% of circulating VitB12/cobalamin. The TCN2:VitB12 complex is ultimately internalized by cells expressing a membrane-bound, 58 kDa TCN2 receptor termed TCblR. Once internalized, VitB12 is released and converted into cofactors that are involved in methionine biosynthesis. Human TCN2 is synthesized as a 427 amino acid (aa) precursor that contains an 18 aa signal sequence, plus a 409 aa mature region that binds one VitB12 molecule. There are three potential splice variants of TCN2. One contains a Trp substitution for aa 116-143, a second possesses an Ile substitution for aa 336-427, and a third shows a deletion of aa 143-193. There is one Arg-to-Pro transition at position 259 that is correlated with statistically elevated circulating levels of TCN2. Over aa 19-427, human TCN2 shares 72% aa sequence identity with mouse TCN2.
Alternate Names
Gene Symbol
UniProt
Additional Transcobalamin II Products
Product Documents for Human Transcobalamin II Antibody
Product Specific Notices for Human Transcobalamin II Antibody
For research use only